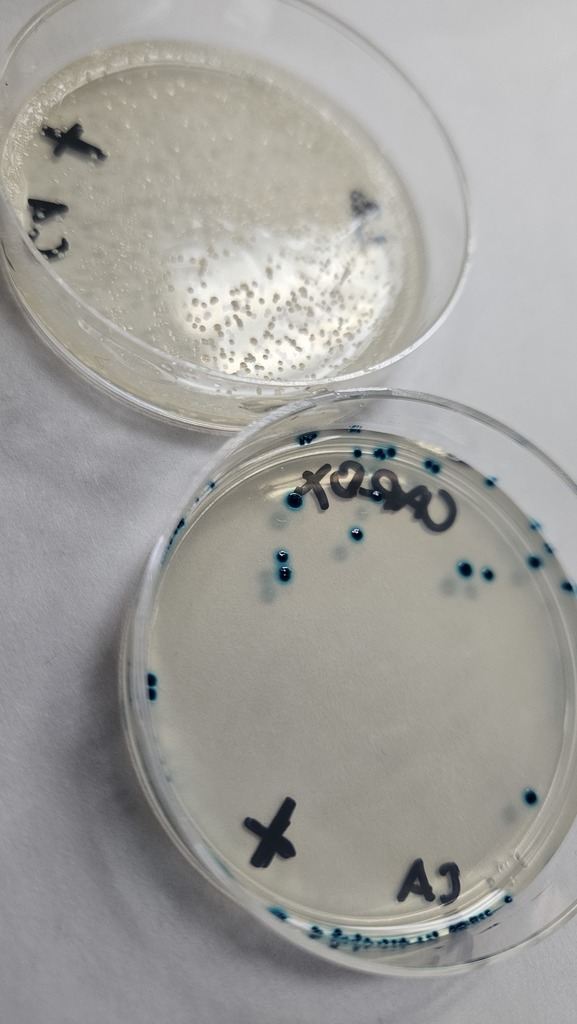
Pictured are petri dishes. One has white bacteria and the other has the bacteria stained blue.

At last night's girls varsity basketball game at Tri-County, Alysa Dittamore broke the school record of rebounds in a game with 33 rebounds! The old record was 31. Congratulations, Alysa!


Things got heated in the kitchen as our Foods II classes faced off in a chili cook-off! Groups selected a recipe and worked together to cook it just right. After a round of tasting by students and guest judges, the winners have been selected. They are: Gavin Keyser, Logan Gerhardt, Konnor McKelvey, and Kade McMechan (1st hour), Lance Lock, Griffin Saylor, and Kenny Willis (3rd hour), and Jackie Butler, Kyndal Duvall, Lily McKerrow, and Layla Holsapple (5th hour). Congratulations to our winning chefs! 🌶️👨🍳




Today, the students in Mrs. Gibson's science classes honored Charles Darwin’s birthday! The classes completed a camouflage activity, designing butterflies that "disappeared" into their environment, showing how animal traits have adapted and evolved for survival. The students also enjoyed some animal-themed treats to represent the biodiversity found on the planet.










Good luck to the CHS wrestlers competing in the IHSA Sectional this weekend! The girls will be at the North Mac Sectional, and the boys will be at the Vandalia Sectional. Both compete on Friday, 2/13, and Saturday, 2/14. Go Pirates! 🏴☠️
Upgrade complete. From Foods II students to chefs! 👨🍳

The CHS varsity boys basketball team will compete in the Wooden Shoe Shootout on Saturday, February 14. The Pirates will play Okaw Valley at 11 AM. Admission is $5. Go Pirates! 🏴☠️

Attention 8th Grade Families!
High school prep starts next week! Students will get their information packets on Tuesday, Feb 17. Join us the following night, Wednesday, Feb 18, at 6:00 PM in the HS Cafeteria for Freshman Orientation.
Note: Please bring your Tuesday packet and any questions you have to the meeting. See you there!
High school prep starts next week! Students will get their information packets on Tuesday, Feb 17. Join us the following night, Wednesday, Feb 18, at 6:00 PM in the HS Cafeteria for Freshman Orientation.
Note: Please bring your Tuesday packet and any questions you have to the meeting. See you there!
The BIO 1 students celebrated Valentine’s week by breaking down a strawberry's cell walls and pulling out those wonderful DNA strands! Happy (almost) Valentine’s Day from the science lab! 🍓❤️



The CHS girls' basketball team will play its first IHSA Regional game on Monday, February 16. Cumberland will play the winner of the Casey/Unity Christian game at 6 PM on Monday at Casey-Westfield High School. Ticket prices are $8 for the semifinal and championship games. Parking will be available in the lot on the north side of the school, along the street in front of the school on the south side, or in the parking lot on the south side of the tennis courts. Go Lady Pirates! 🏴☠️

Attention Seniors! Lake Land College will select one lucky Cumberland Senior to win a tuition waiver at the Feb. 17th basketball game. All seniors who attend the basketball game will receive a raffle ticket. At halftime, Lake Land will select a winner. You must be present to win.

IHSA Wrestling Sectional meet information:
The boys' qualifiers will compete at the Vandalia Sectional on Friday, 2/13, and Saturday, 2/14. Tickets are $9.40 per session through GoFan or $10/session at the door. Use this link to access GoFan: https://gofan.co/app/school/IL24064
The girls' qualifiers will compete at the North Mac Sectional in Virden on Friday, 2/13, and Saturday, 2/14. Tickets are $9.40 per session on GoFan or $ 10.00 at the door. Use this link to access GoFan: https://gofan.co/app/school/IL50279
Go Pirates! 🏴☠️
The boys' qualifiers will compete at the Vandalia Sectional on Friday, 2/13, and Saturday, 2/14. Tickets are $9.40 per session through GoFan or $10/session at the door. Use this link to access GoFan: https://gofan.co/app/school/IL24064
The girls' qualifiers will compete at the North Mac Sectional in Virden on Friday, 2/13, and Saturday, 2/14. Tickets are $9.40 per session on GoFan or $ 10.00 at the door. Use this link to access GoFan: https://gofan.co/app/school/IL50279
Go Pirates! 🏴☠️
Mrs. Gibson's microbiology students recently practiced Gram staining, a basic diagnostic technique used to classify bacteria. In this process, the students were able to observe how the different cell walls retained certain dyes.





This is a friendly reminder that on Friday, February 13, school will dismiss at 12:01 for a teacher in-service. On Monday, 2/16, there will be no school in observance of Presidents' Day.

It was a packed house at CHS this past Saturday! With the band playing and cheerleaders leading the charge, the energy was high as both the girls' and boys' varsity teams secured wins over Newton.
Don’t miss your chance to catch these teams! The girls take the home court for the final time tonight at 6 PM, and the boys have just two home games left on 2/17 and 2/20. Come out and show your support!
Don’t miss your chance to catch these teams! The girls take the home court for the final time tonight at 6 PM, and the boys have just two home games left on 2/17 and 2/20. Come out and show your support!







CHS Scholastic Bowl attended the Frostbite Tournament in Granite City on February 7th and placed 4th overall! Camden James and Rylan James were selected to the All-Tournament team! Way to go, Pirates! 🏴☠️


In BIO 2, students are exploring the world of Biotechnology. Last week, they completed a Bacterial Transformation lab. Through the process, they turned bacteria blue! This is the same process used to make insulin!

Congratulations to CHS wrestlers Natalie Beaumont and Summer Nichols on advancing to the IHSA sectional next weekend. Natalie placed 1st and Summer placed 3rd at today's regional! Go Pirates! 🏴☠️


Super Bowl Weekend Reminder from S.A.D.D.
Fans Don’t Let Fans Drive Drunk.
As Super Bowl celebrations approach, S.A.D.D. is proud to support the U.S. Department of Transportation and NHTSA’s Fans Don’t Let Fans Drive Drunk campaign. It’s a reminder that making safe choices saves lives—and looking out for others matters.
Plan Ahead for a Safe Celebration:
*Always drive 100% sober - one drink is one too many
*Plan ahead and choose a sober driver before the celebration begins
*Use safe options like a designated driver, taxi, or rideshare
* If you’re the designated driver, take the responsibility seriously and don’t drink
* If you see a drunk driver, contact local law enforcement
*Look out for friends - never let someone drive impaired
Celebrate the game. Protect your friends. Get home safely.
Fans Don’t Let Fans Drive Drunk.
As Super Bowl celebrations approach, S.A.D.D. is proud to support the U.S. Department of Transportation and NHTSA’s Fans Don’t Let Fans Drive Drunk campaign. It’s a reminder that making safe choices saves lives—and looking out for others matters.
Plan Ahead for a Safe Celebration:
*Always drive 100% sober - one drink is one too many
*Plan ahead and choose a sober driver before the celebration begins
*Use safe options like a designated driver, taxi, or rideshare
* If you’re the designated driver, take the responsibility seriously and don’t drink
* If you see a drunk driver, contact local law enforcement
*Look out for friends - never let someone drive impaired
Celebrate the game. Protect your friends. Get home safely.
Congratulations to Jade Carr on signing her letter of intent to continue her academic and athletic career at Lake Land College!

Congratulations to th e CHS ACES team, who earned 2nd place today at their competition at Lake Land College! Individual ACES awards went to:
Rylan James, 3rd Place in Biology
Mitchell Blade, 2nd Place in Chemistry
Addison Johnson, 1st Place in Chemistry
Jonah Tibbs, 1st Place in Computer Science
Jonah Tibbs, 3rd Place in English
Mitchell Blade, 2nd Place in Math
Rylan James, 3rd Place in Biology
Mitchell Blade, 2nd Place in Chemistry
Addison Johnson, 1st Place in Chemistry
Jonah Tibbs, 1st Place in Computer Science
Jonah Tibbs, 3rd Place in English
Mitchell Blade, 2nd Place in Math

